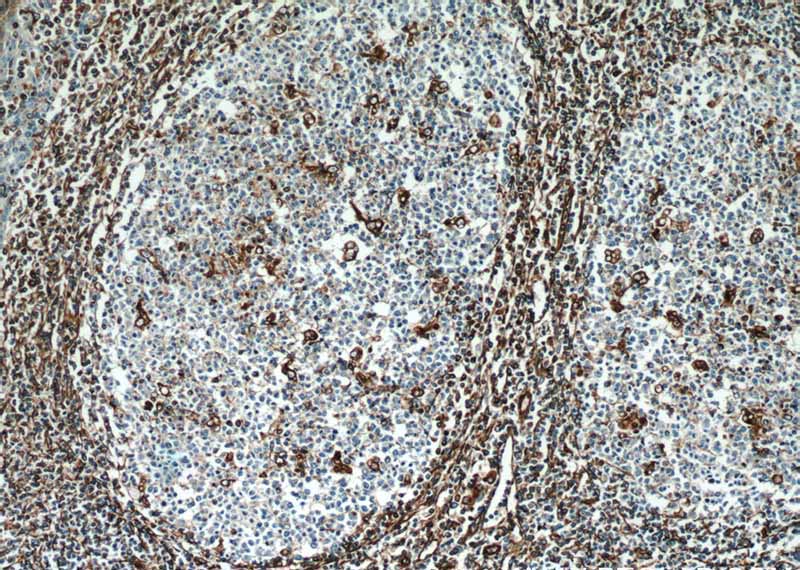
Immunohistochemical of paraffin-embedded human tonsillitis using Catalog No:116753(VIM antibody) at dilution of 1:50 (under 10x lens)
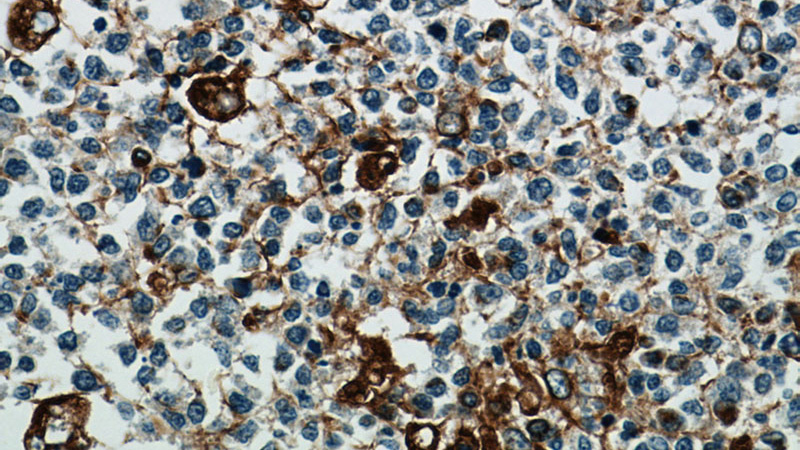
Immunohistochemical of paraffin-embedded human tonsillitis using Catalog No:116753(VIM antibody) at dilution of 1:50 (under 40x lens)

-
Product Name
Vimentin antibody
- Documents
-
Description
Vimentin Rabbit Polyclonal antibody. Positive WB detected in NIH/3T3 cells, A549 cells, HeLa cells, Jurkat cells, mouse heart tissue, Raji cells, rat heart tissue. Positive IHC detected in human tonsillitis tissue, human cervical cancer tissue, human colon tissue, human endometrial cancer tissue, human gliomas tissue, human liver tissue, human lung cancer tissue, human lymphoma tissue, human meningioma tissue, human ovary tumor tissue, human renal cell carcinoma tissue. Positive IF detected in HepG2 cells. Positive FC detected in HeLa cells. Observed molecular weight by Western-blot: 54 kDa
-
Tested applications
ELISA, IF, IHC, WB, FC
-
Species reactivity
Human,Mouse,Rat; other species not tested.
-
Alternative names
VIM antibody; vimentin antibody
-
Isotype
Rabbit IgG
-
Preparation
This antibody was obtained by immunization of Vimentin recombinant protein (Accession Number: XM_006717500). Purification method: Antigen affinity purified.
-
Clonality
Polyclonal
-
Formulation
PBS with 0.02% sodium azide and 50% glycerol pH 7.3.
-
Storage instructions
Store at -20℃. DO NOT ALIQUOT
-
Applications
Recommended Dilution:
WB: 1:1000-1:10000
IHC: 1:20-1:200
IF: 1:10-1:100
-
Validations
Immunohistochemical of paraffin-embedded human tonsillitis using Catalog No:116753(VIM antibody) at dilution of 1:50 (under 10x lens)

NIH/3T3 cells were subjected to SDS PAGE followed by western blot with Catalog No:116753(VIM antibody) at dilution of 1:2000

Immunofluorescent analysis of HepG2 cells, using VIM antibody Catalog No:116753 at 1:25 dilution and Rhodamine-labeled goat anti-rabbit IgG (red).
Immunohistochemical of paraffin-embedded human tonsillitis using Catalog No:116753(VIM antibody) at dilution of 1:50 (under 40x lens)

1X10^6 HeLa cells were stained with 0.2ug Vimentin antibody (Catalog No:116753, red) and control antibody (blue). Fixed with 4% PFA blocked with 3% BSA (30 min). Alexa Fluor 488-congugated AffiniPure Goat Anti-Rabbit IgG(H+L) with dilution 1:1000.
-
Background
Vimentin, also named as VIM, belongs to the intermediate filament family. Vimentin is class-III intermediate filaments found in various non-epithelial cells, especially mesenchymal cells. Vimentin is important for stabilizing the architecture of the cytoplasm. Monocyte-derived macrophages secrete vimentin into the extracellular space in vitro. Secretion of vimentin was enhanced by the proinflammatory cytokine tumor necrosis factor-alpha (TNFA; 191160) and inhibited by the antiinflammatory cytokine IL10 (124092), suggesting that vimentin is involved in the immune response. Vimentin has specialized functions that contribute to specific dynamic cellular processes. As a phosphoprotein, 55-60 kDa of vimentin proteins can be observed due to the different phosphorylation level.
-
References
- Zhao XY, Chen TT, Xia L. Hypoxia inducible factor-1 mediates expression of galectin-1: the potential role in migration/invasion of colorectal cancer cells. Carcinogenesis. 31(8):1367-75. 2010.
- Toh B, Wang X, Keeble J. Mesenchymal transition and dissemination of cancer cells is driven by myeloid-derived suppressor cells infiltrating the primary tumor. PLoS biology. 9(9):e1001162. 2011.
- Wu J, Wu G, Lv L. MicroRNA-34a inhibits migration and invasion of colon cancer cells via targeting to Fra-1. Carcinogenesis. 33(3):519-28. 2012.
- Zhu L, Qin H, Li PY. Response gene to complement-32 enhances metastatic phenotype by mediating transforming growth factor beta-induced epithelial-mesenchymal transition in human pancreatic cancer cell line BxPC-3. Journal of experimental & clinical cancer research : CR. 31:29. 2012.
- Shen C, Yu Y, Li H. Global profiling of proteolytically modified proteins in human metastatic hepatocellular carcinoma cell lines reveals CAPN2 centered network. Proteomics. 12(12):1917-27. 2012.
- Ding J, Jin W, Chen C, Shao Z, Wu J. Tumor associated macrophage × cancer cell hybrids may acquire cancer stem cell properties in breast cancer. PloS one. 7(7):e41942. 2012.
- Liu Y, Du J, Zhang J. Snail1 is involved in de novo cardiac fibrosis after myocardial infarction in mice. Acta biochimica et biophysica Sinica. 44(11):902-10. 2012.
- Yao W, Fan W, Huang C, Zhong H, Chen X, Zhang W. Proteomic analysis for anti-atherosclerotic effect of tetrahydroxystilbene glucoside in rats. Biomedicine & pharmacotherapy = Biomédecine & pharmacothérapie. 67(2):140-5. 2013.
Related Products / Services
Please note: All products are "FOR RESEARCH USE ONLY AND ARE NOT INTENDED FOR DIAGNOSTIC OR THERAPEUTIC USE"
